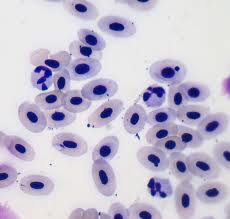

Este virus es conocido como el que provoca que el hombre sufra dolor tan intenso que llega a debilitar tanto que la persona no es capaz de moverse. La palabra Chikungunya proviene el idioma Kimakoke y el significado de esta palabra es “retorcerse o doblarse” en descripción de la posición de los infectados por este virus.
 Se trata de un virus de proviene de África, Asia y el subcontinente indio que se transmite a través del vector mosquito infectado, el mosquito tigre hembra. La importancia de hablar de este virus en este post es que desde el primer caso de este Chikungunya en Europa en el año 2007 con un brote localizado en el sur de Italia, los casos han aumentado en Europa y en España en lo que llevamos de año ha habido 39 casos por lo que debemos de conocer su existencia, sus síntomas y como tratarlo.
Se trata de un virus de proviene de África, Asia y el subcontinente indio que se transmite a través del vector mosquito infectado, el mosquito tigre hembra. La importancia de hablar de este virus en este post es que desde el primer caso de este Chikungunya en Europa en el año 2007 con un brote localizado en el sur de Italia, los casos han aumentado en Europa y en España en lo que llevamos de año ha habido 39 casos por lo que debemos de conocer su existencia, sus síntomas y como tratarlo.
Transmisión
Como hemos comentado el vector del virus es el mosquito tigre hembra, más concretamente Aedes aegypti y Aedes albopictus mosquitos que portan también otros virus como el dengue. El mosquito tigre es un mosquito que en España es frecuente y se localiza en el área mediterránea donde han adquirido un hábitat natural y conviven con lo humanos de forma natural. Esto tiene la importancia de que si un portador mosquito Chikungunya se asentara en alguna de las zonas donde el mosquito tigre está asentado durante los meses de mayor temperatura puede ocasionar un aumento de casos pero tenemos la ventaja de que quedaría erradicado por las bajas temperaturas que alcanzamos en invierno, pues no hay que olvidar que es un virus de procedencia de clima cálido. No se considera como una alarma social pese a la sintomatología que desencadena ya que en España hasta la fecha no ha habido casos de mortalidad, pero en otras zonas donde el clima es cálido, como por ejemplo, las Islas del Caribe la situación es grave donde hay unos 5.000 casos y donde la mortalidad comienza a aumentar con 21 fallecidos.
Si es cierto que con mayor frecuencia el número de países afectados es más considerable,  pues ya afecta a casi 41 países de Asia, África, Europa y Américas, y afecta a personas vulnerables como ancianos, niños e inmunodeprimidos.
pues ya afecta a casi 41 países de Asia, África, Europa y Américas, y afecta a personas vulnerables como ancianos, niños e inmunodeprimidos.
Signos y síntomas
Este virus produce fiebre alta de más de 40 grados y se complementa con un inicio brusco  y repentino donde aparecen dolores articulares severos, dolores de cabeza, dolores musculares, nauseas, erupciones en piel y cansancio. La aparición del primer síntoma tras el contagio sucede alrededor de una semana y la evolución puede tener una duración de entre 12 y 60 días. Esta infección produce recuelas como dolor en articulaciones y músculos y cefaleas durante 2 años. En ocasiones es confundido con el dengue o la fiebre amarilla por la similitud en su sintomatología y por coincidir en el tipo de mosquito que porta estos virus, aunque este es menos virulento, si el contagio se produce en zonas frecuentes de contagio por dengue.
y repentino donde aparecen dolores articulares severos, dolores de cabeza, dolores musculares, nauseas, erupciones en piel y cansancio. La aparición del primer síntoma tras el contagio sucede alrededor de una semana y la evolución puede tener una duración de entre 12 y 60 días. Esta infección produce recuelas como dolor en articulaciones y músculos y cefaleas durante 2 años. En ocasiones es confundido con el dengue o la fiebre amarilla por la similitud en su sintomatología y por coincidir en el tipo de mosquito que porta estos virus, aunque este es menos virulento, si el contagio se produce en zonas frecuentes de contagio por dengue.
Diagnóstico y Tratamiento
Para diagnosticar este virus disponemos de varios métodos donde las pruebas serológicas  utilizando la el método ELISA se obtienen los anticuerpos en nuestro organismo si hemos estado en contacto con este virus. Dado que el virus puede pasar inadvertido durante la primera sema es recomendable someterse a pruebas virológicas como RT-PCR donde obtendremos la proteína plasmática circulante la cual aumenta en presencia de inflamación causas por una infección.
utilizando la el método ELISA se obtienen los anticuerpos en nuestro organismo si hemos estado en contacto con este virus. Dado que el virus puede pasar inadvertido durante la primera sema es recomendable someterse a pruebas virológicas como RT-PCR donde obtendremos la proteína plasmática circulante la cual aumenta en presencia de inflamación causas por una infección.
Este virus como tantos otros no tiene cura, por lo que el tratamiento irá encaminado a la paliación de los síntomas. Se utilizarán analgésicos para el dolor y antipiréticos para la fiebre, y donde la hidratación será fundamental.
¿Si no hay tratamiento que debemos hacer?
Al igual que en todas las enfermedades el mejor remedio es la prevención y evitar el contagio. Las personas que decidan viajar a zonas de clima cálido es aconsejable que utilicen ropa de color claro y de manga larga, evitando salir entre el atardecer y el amanecer, pues son las horas en las que el mosquito actúa, y muy importante la utilización de repelentes para mosquitos.
En España este tipo de casos se aconseja que si comienza con la sintomatología descrita y tiene la sospecha de que un mosquito le ha picado debe de acudir a un servicios de atención especializa. Por parte de los servicios especializados deberán de establecer un control riguroso pues se trata de un plan de iniciativa con carácter especial.
Categorizado en:
Biosanitario